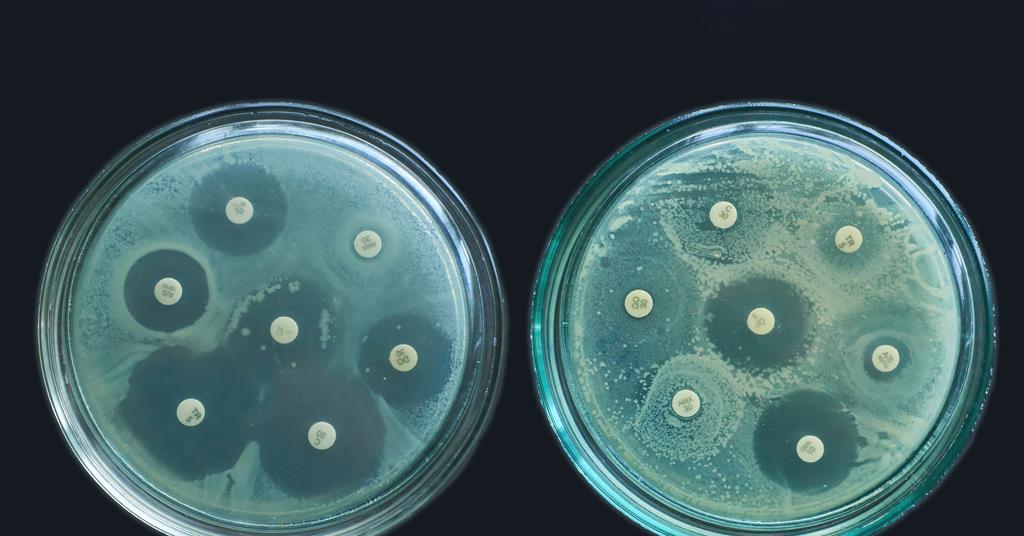

[ad_1]
A novel synthetic antibiotic with a structure preorganised for optimal ribosomal binding has been shown to be effective against several multi-drug resistant strains of bacteria. The researchers hope their findings will support the future discovery of antibacterial agents broadly effective against antimicrobial resistance.

Lincosamide antibiotics, such as clindamycin, work by binding to the bacterial ribosome, arresting protein synthesis. However, bacterial evolution has produced many ribosome modifications that confer resistance by reducing the binding affinity of these antibiotics, rendering them ineffective.
To find a way to overcome this challenge, the researchers, who were from Andrew Myers’ research group in the department of chemistry and chemical biology at Harvard University in the US, took a newly developed lincosamide that they had previously reported – iboxamycin – and examined its conformation while bound to the bacterial ribosome.
‘We observed atoms that were quite close to each other and decided that it might be feasible to link those together, resulting in a pre-organised or pre-rigidified conformation that most closely resembles how it will look when bound to the bacterial ribosome,’ explains Kelvin Wu, a chemistry graduate student in Myers’ group and first author on the study.
‘If a molecule is very flexible with many rotatable bonds, it incurs a significant entropy cost to freeze those bonds when the molecule binds to the bacterial ribosome,’ Wu says. ‘By pre-organising a molecule into its preferred binding conformation, you can reduce the entropy cost of binding to its target which then translates to an increase in free energy and a stronger binding interaction.’

Conformational restriction of the aminooctose residue of iboxamycin through transannular macrocyclisation led to the formation of cresomycin, a new antibiotic pre-organised for binding to the bacterial ribosome. Results from in vitro studies suggested that cresomycin had efficacy against both Gram-positive and Gram-negative bacteria, including those on the World Health Organization’s priority pathogen list, such as carbapenem-resistant Escherichia coli and Pseudomonas aeruginosa. This efficacy was also demonstrated in in vivo studies using mouse models.
Stephen Cochrane, reader in organic chemistry and chemical biology at Queen’s University Belfast, describes cresomycin as a ‘very promising lead’. ‘It’s a nice use of rational design coupled with computational aids to create a new analog of lincomycin,’ he adds. ‘It’s not a new class of antibiotic because it is still based on something that’s operating by the same mechanism but it’s a nice use of that approach to give us something new.’
‘The positive with any new antimicrobial compound that’s active against current resistant strains is that we have a new weapon in the arsenal. It’s also overcoming known resistance mechanisms for macrolides and lincosamide antibiotics – such as lincomycin or erythromycin – which kill bacteria by binding to the ribosome.’
Cochrane highlights several limitations which, he says, would need to be addressed before the compound could make its way to the clinic. ‘The big glaring one is the effort required to access it through total synthesis – the whole process, at least by my calculations, is approximately 0.8% yield for approximately 25 steps. And some of these steps use toxic reagents, extremely cold temperatures, chiral auxiliaries etc – so as it stands, it would need a lot of modifications and optimisations to be something that could be scaled.’
Study author Ben Tresco acknowledge that the current synthesis route for cresomycin is difficult to scale up. ‘Once we know that these compounds work, we spend a lot of time developing what we’d consider a scalable synthesis,’ he explains. ‘I’m happy to say that we’ve been successful in this effort – we now have an entirely different route that allows us to access these really complex molecules on multi-gram scale.’
Cochrane also says that to ‘future proof’ the compound it would be important to investigate the likelihood of resistance mechanisms developing over a longer time frame than was tested in the study.
On 13 February, the Combating Antibiotic-Resistant Bacteria Biopharmaceutical Accelerator announced that Myers’ group will receive $1.2 million (£950,000) in funding to develop a series of enhanced oral antibiotics that directly target a range of antibiotic-resistant bacteria which cause serious lower respiratory tract and skin and soft tissue infections.
[ad_2]
Source link
Leave a Reply